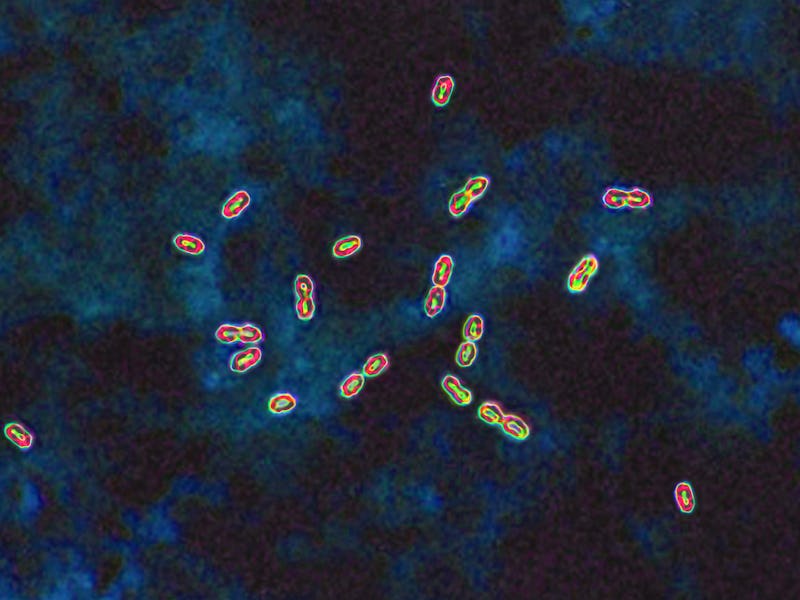

Inside A Wild Method to Resurrect Ancient Molecules And Concoct New Antibiotics
Fossilized microbes could be a source of new drugs.
Microorganisms — in particular, bacteria — are skillful chemists that can produce an impressive diversity of chemical compounds known as natural products. These metabolites provide the microbes major evolutionary advantages, such as allowing them to interact with one another or their environment and helping defend against different threats. Because of the diverse functions natural bacterial products have, many have been used as medical treatments, such as antibiotics and anti-cancer drugs.
The microbial species alive today represent only a tiny fraction of the vast diversity of microbes that have inhabited Earth over the past 3 billion years. Exploring this microbial past presents exciting opportunities to recover some of their lost chemistry.
Directly studying these metabolites in archaeological samples is virtually impossible because of their poor preservation over time. However, reconstructing them using the genetic blueprints of long-dead microbes could provide a path forward.
We are a team of anthropologists, archaeogenetics, and biochemists who study ancient microbes. By generating previously unknown chemical compounds from the reconstructed genomes of ancient bacteria, our newly published research provides a proof of concept for the potential use of fossil microbes as a source of new drugs.
Reconstructing ancient genomes
The cellular machinery producing natural bacterial products is encoded in genes that are typically in close proximity to one another, forming what are called biosynthetic gene clusters. Such genes are difficult to detect and reconstruct from ancient DNA because very old genetic material breaks down over time, fragmenting into thousands or even millions of pieces. The end result is numerous tiny DNA fragments less than 50 nucleotides long, all mixed together like a jumbled jigsaw puzzle.
We sequenced billions of such ancient DNA fragments, then improved a bioinformatic process called de novo assembly to digitally order the ancient DNA fragments in stretches of up to 100,000 nucleotides long – a 2,000-fold improvement. This process allowed us to identify not only what genes were present but also their order in the genome and the ways they differ from bacterial genes known today – key information to uncovering their evolutionary history and function.
This method allowed us to take an unprecedented look at the genomes of microbes living up to 100,000 years ago, including species not known to exist today. Our findings push back the previously oldest reconstructed microbial genomes by more than 90,000 years.
In the microbial genomes we reconstructed from DNA extracted from ancient tooth tartar, we found a gene cluster that was shared by a high proportion of Neanderthals and anatomically modern humans living during the Middle and Upper Paleolithic that lasted from 300,000 to 12,000 years ago. This cluster bore the molecular hallmarks of very ancient DNA and belonged to the bacterial genus Chlorobium, a group of green sulfur bacteria capable of photosynthesis.
We inserted a synthetic version of this gene cluster into a “modern” bacterium called Pseudomona protegens so it could produce the chemical compounds encoded in the ancient genes. Using this method, we were able to isolate two previously unknown compounds we named paleofuran A and B and determine their chemical structure. Resynthesizing these molecules in the lab from scratch confirmed their structure and allowed us to produce larger quantities for further analysis.
By reconstructing these ancient compounds, our findings highlight how archaeological samples could serve as new sources of natural products.
Mining ancient natural products
Microbes are constantly evolving and adapting to their surrounding environment. Because the environments they inhabit today differ from those of their ancestors, microbes today likely produce different natural products than ancient microbes from tens of thousands of years ago.
As recently as 25,000 to 10,000 years ago, the Earth underwent a major climate shift as it transitioned from the colder and more volatile Pleistocene Epoch to the warmer and more temperate Holocene Epoch. Human lifestyles also dramatically changed over this transition as people began living outside of caves and increasingly experimented with food production. These changes brought them into contact with different microbes through agriculture, animal husbandry, and their newly built environments. Studying Pleistocene-era bacteria may yield insights into bacterial species and biosynthetic genes no longer associated with humans today and perhaps even microbes that have gone extinct.
While the amount of data collected by scientists on biological organisms has exponentially increased over the past few decades, the number of new antibiotics has stagnated. This is particularly problematic when bacteria are able to evade existing antibiotic treatments faster than researchers can develop new ones.
By reconstructing microbial genomes from archaeological samples, scientists can tap into the hidden diversity of natural products that would have otherwise been lost over time, increasing the number of potential sources from which they can discover new drugs.
Scaling up ancient molecules
Our study has shown that it is possible to access natural products from the past. To tap into the vast diversity of chemical compounds encoded in ancient DNA, we now need to streamline our methodology to be less labor-intensive.
We are currently optimizing and automating our process to identify biosynthetic genes in ancient DNA more quickly and reliably. We are also implementing robotic liquid handling systems to complete the time-consuming pipetting and bacterial cultivation steps in our methods. Our goal is to scale up the process to be able to translate a vast amount of data on ancient microbes into the discovery of new therapeutic agents.
Although we can recreate ancient molecules, their biological and ecological roles are difficult to decipher. Since the bacteria that originally produced these compounds no longer exist, we cannot culture or genetically manipulate them. Further study will need to rely on similar bacteria that can be found today. Whether or not the functions of these compounds have remained the same in the modern relatives of ancient microbes remains to be tested. Although the original functions of these compounds for ancient microbes may be unknown, they still have the potential to be repurposed to treat modern diseases.
Ultimately, we aim to shed new light on microbial evolution and fight the current antibiotic crisis by providing a new time axis for antibiotic discovery.
This article was originally published on The Conversation by Christina Warinner at Harvard University, Alexander Hübner at Max Planck Institute for Evolutionary Anthropology, and Pierre Stallforth at Friedrich-Schiller-Universität Jena. Read the original article here.
This article was originally published on